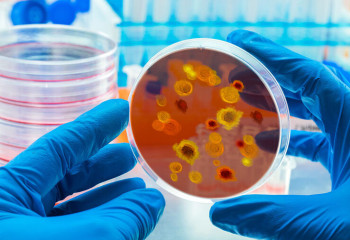
Қытайда өршіген чикунгунья эпидемиясынан қауіп бар ма?

14.08.2025
eGov Mobile қосымшасы жаңарды: қандай артықшылықтары бар?

14.08.2025
eGov Mobile қосымшасы жаңарды: қандай артықшылықтары бар?
14.08.2025
Оқушы сөмкесінің салмағы қандай болуы керек?
14.08.2025
Несие төлеуді кешіктірдіңіз бе? Қарызды заң жүзінде реттеуге болады
13.08.2025
Мектеп формасын қалай таңдау керек? Министрлік түсіндірді
13.08.2025
Қазақстанда мемлекеттік наградаға ұсыну ережесі өзгерді
13.08.2025
Fonte Capital компаниясы Орталық Азиядағы алғашқы споттық биткоин ұсынды
13.08.2025
Баспана бағасында қандай өзгерістер болуы мүмкін?
13.08.2025
Қуырылған картоптың денсаулыққа қаупі қандай?
13.08.2025
Қазақстанда магистратураға құжат қабылдау басталды
13.08.2025
Қытайлық көліктердің қауіпті екені анықталды
12.08.2025
Қытайда өршіген чикунгунья эпидемиясынан қауіп бар ма?
12.08.2025
Мыңдаған қазақстандықтарға несие берілмеуі мүмкін: талаптар қандай?